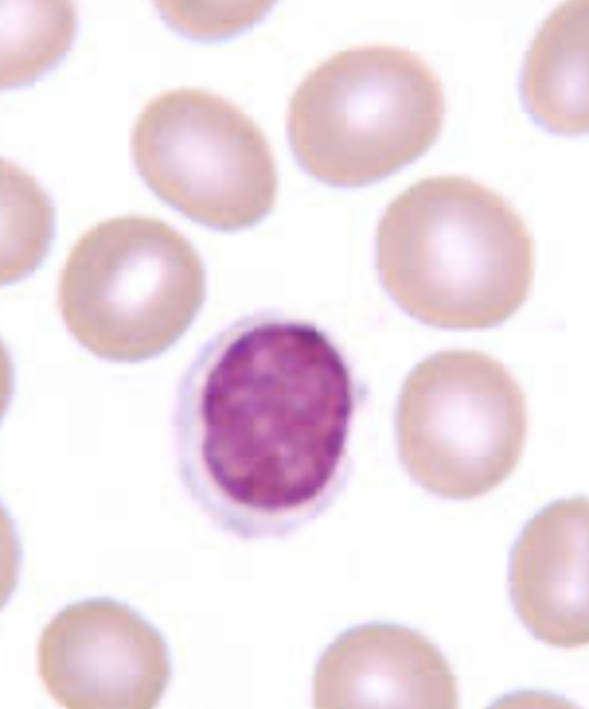
<p>nucleus fills up almost the whole cell and leaves a sliver of cytoplasm </p><ul><li><p>dont confuse with basophil (these are smooth) </p></li></ul><p></p>
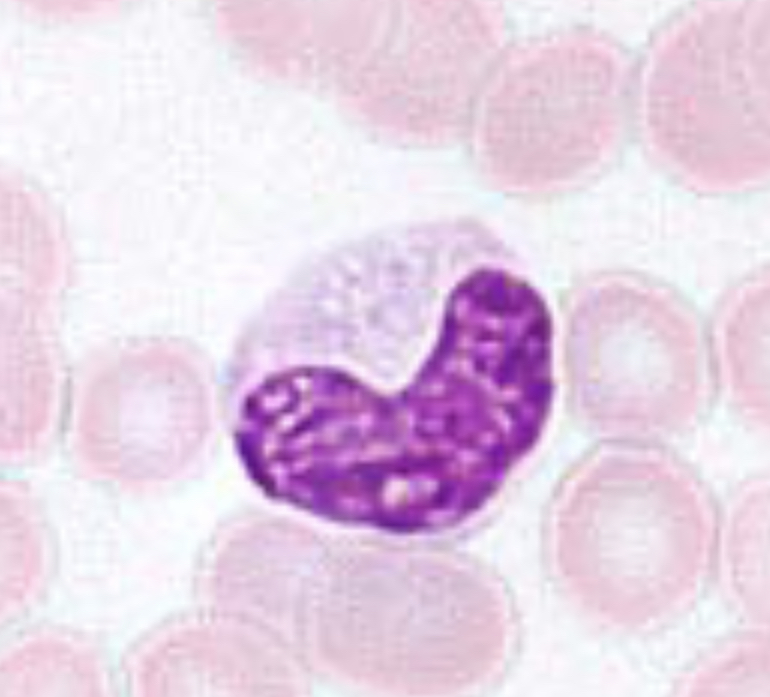
<p>nucleus is horseshoe or kidney bean shaped </p><ul><li><p>nucleus can spin so it might be “c” or “n” shaped </p><ul><li><p>dont confuse with neutrophil… look for the UNIFORM thickness of this nucleus </p></li></ul></li></ul><p></p>
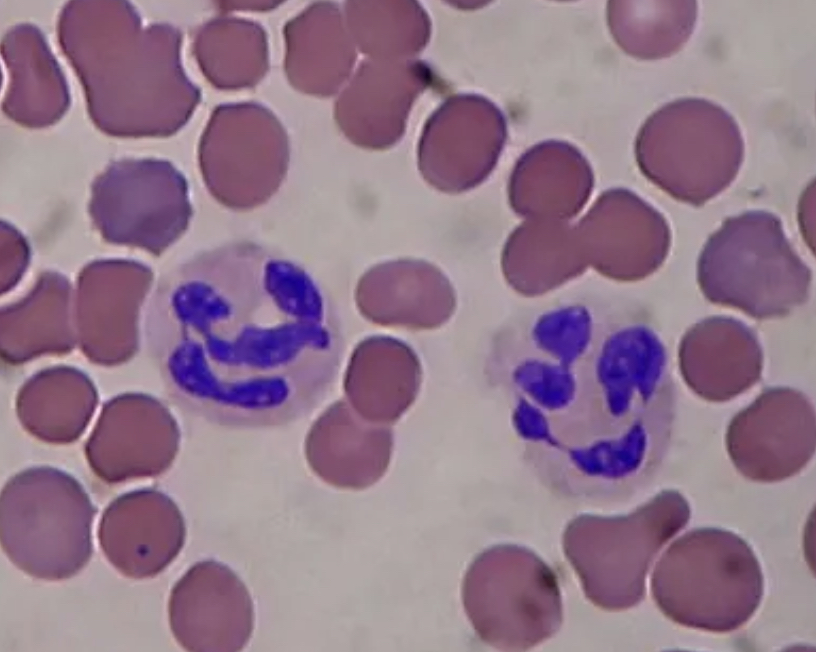
<p>the nucleus looks like a chain of sausages “thick-thin-thick-thin” </p><ul><li><p>no 2 of these look exactly alike </p></li><li><p>somethings the thin area of the sausage might not stain so the sausage looks detached </p><ul><li><p>dont confuse with monocyte… look at the thickness of nucleus sausage </p></li></ul></li></ul><p></p>
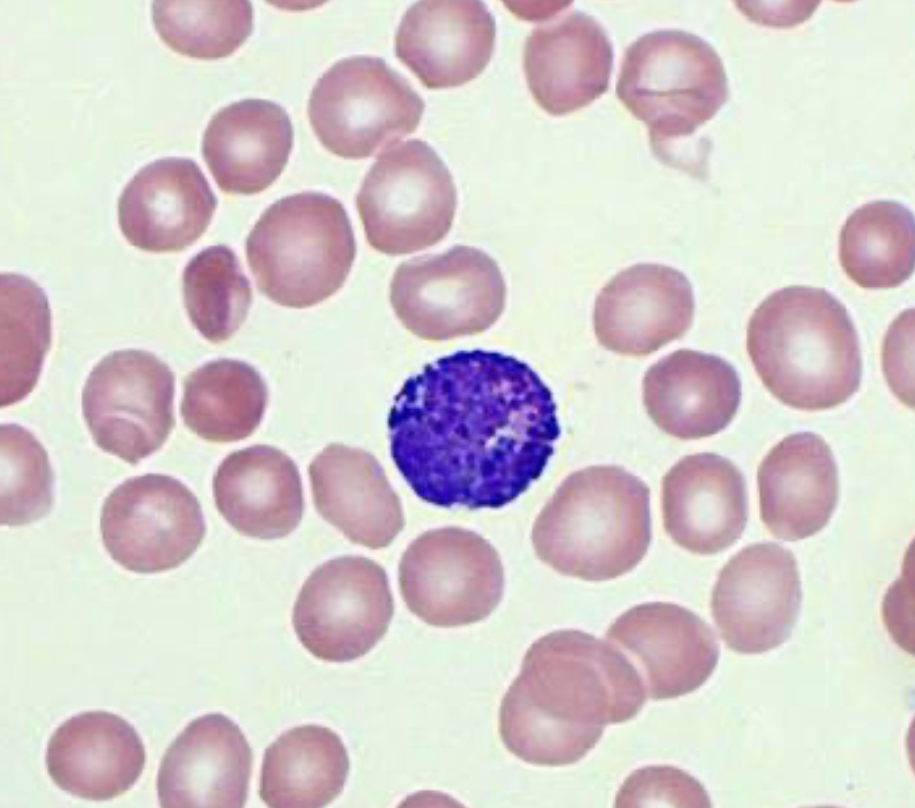
<p>full of granules- can’t see the nucleus because the granules cover it</p><ul><li><p>lumpy texture</p></li><li><p>bumpy on the sides of the cell because of granules</p><ul><li><p>dont confuse with lymphocyte</p></li></ul></li></ul><p></p>
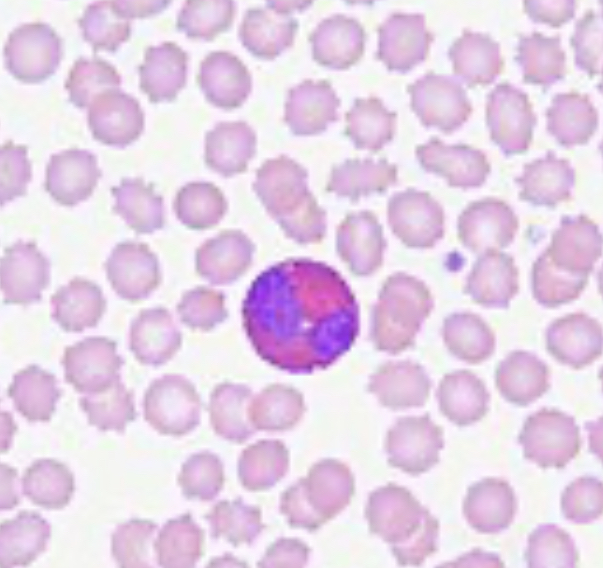
<p>bilobed nucleus (looks like lungs) </p><ul><li><p>2 dark sections in its nucleus </p></li><li><p>has orange/ red granules in the cytoplasm </p></li></ul><p></p>

1/7
Looks like no tags are added yet.
Name | Mastery | Learn | Test | Matching | Spaced | Call with Kai |
|---|
No analytics yet
Send a link to your students to track their progress
platelets always stain
dark (dark red, or purple)
how can you tell the difference between RBC’s and WBC’s
look at the nucleus- RBC’s dent have a nucleus
nucleus fills up almost the whole cell and leaves a sliver of cytoplasm
dont confuse with basophil (these are smooth)
lymphocyte
nucleus is horseshoe or kidney bean shaped
nucleus can spin so it might be “c” or “n” shaped
dont confuse with neutrophil… look for the UNIFORM thickness of this nucleus
monocyte
the nucleus looks like a chain of sausages “thick-thin-thick-thin”
no 2 of these look exactly alike
somethings the thin area of the sausage might not stain so the sausage looks detached
dont confuse with monocyte… look at the thickness of nucleus sausage
neutrophil
full of granules- can’t see the nucleus because the granules cover it
lumpy texture
bumpy on the sides of the cell because of granules
dont confuse with lymphocyte
basophil
bilobed nucleus (looks like lungs)
2 dark sections in its nucleus
has orange/ red granules in the cytoplasm
eosinophils
order of abundance for WBCs
neutrophils, lymphocytes, monocytes, eosinophils, basophils
never let monkeys eat bananas